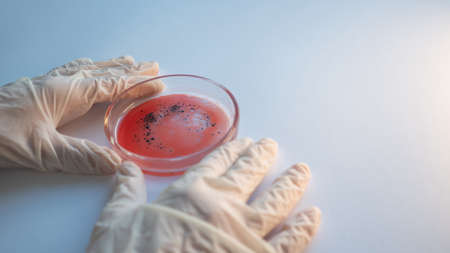
epidemic and the global virus attack concept. lab technician or researcher holds a Petri dish with a sample. Virology and bacteriologyの写真素材

写真素材 - epidemic and the global virus attack concept. lab technician or researcher holds a Petri dish with a sample. Virology and bacteriology
作品情報
epidemic and the global virus attack concept. lab technician or researcher holds a Petri dish with a sample. Virology and bacteriology
- ID:154899720
- 作品種別:写真
- 作者名:Yulia Koltyrina
キーワード
- advanced
- analysis
- bacteria
- bacterial
- bacteriology
- biochemistry
- biological
- biology
- biotechnology
- concept
- culture
- dish
- epidemic viral pathogen
- equipment
- glassware
- gloves
- grow
- hands
- health care
- human
- hygiene
- infection
- lab
- laboratory
- laboratory assistant
- medical
- microbe
- microbiology
- microorganisms
- pandemic
- petri
- petri dish
- research
- sample
- science
- scientific
- scientific research
- scientist
- symbol
- test
- viral
- virology
- virus attack
- viruses
類似作品
A human skull w...
A human skull w...
Coronavirus Cov...
A green barbed ...
woman in protec...
Coronavirus dis...
A male hand in ...
virus global pa...
Coronavirus or ...
Corona virus gl...
red medical mas...
Pandemic virus ...
3D dot world ma...
Businessmen ign...
Hazmat doctors ...
virus in the wo...
Earth globe and...
Creative concep...
A male hand in ...
Corona virus gl...
A male hand in ...
Covid-19, Covid...
Corona virus gl...
blood dna of s...
Globe in a medi...
Over 1 million....
Kid hold globe ...
corona virus ma...
Globe Coronovir...
COVID-19 hotspo...
Perfume on self...
COVID-19 Busine...
COVID-19, Coron...
The male hand i...
Green toy army ...
Omicron covid-1...
Digital world m...
woman in protec...
hands with blue...
Coronavirus 201...
Covid molecules...
New Coronavirus...
sphere of the p...
Globe Shaped Co...
Stop COVID-19 C...
Corona virus gl...
epidemic corona...
A pandemic of c...
Coronavirus and...